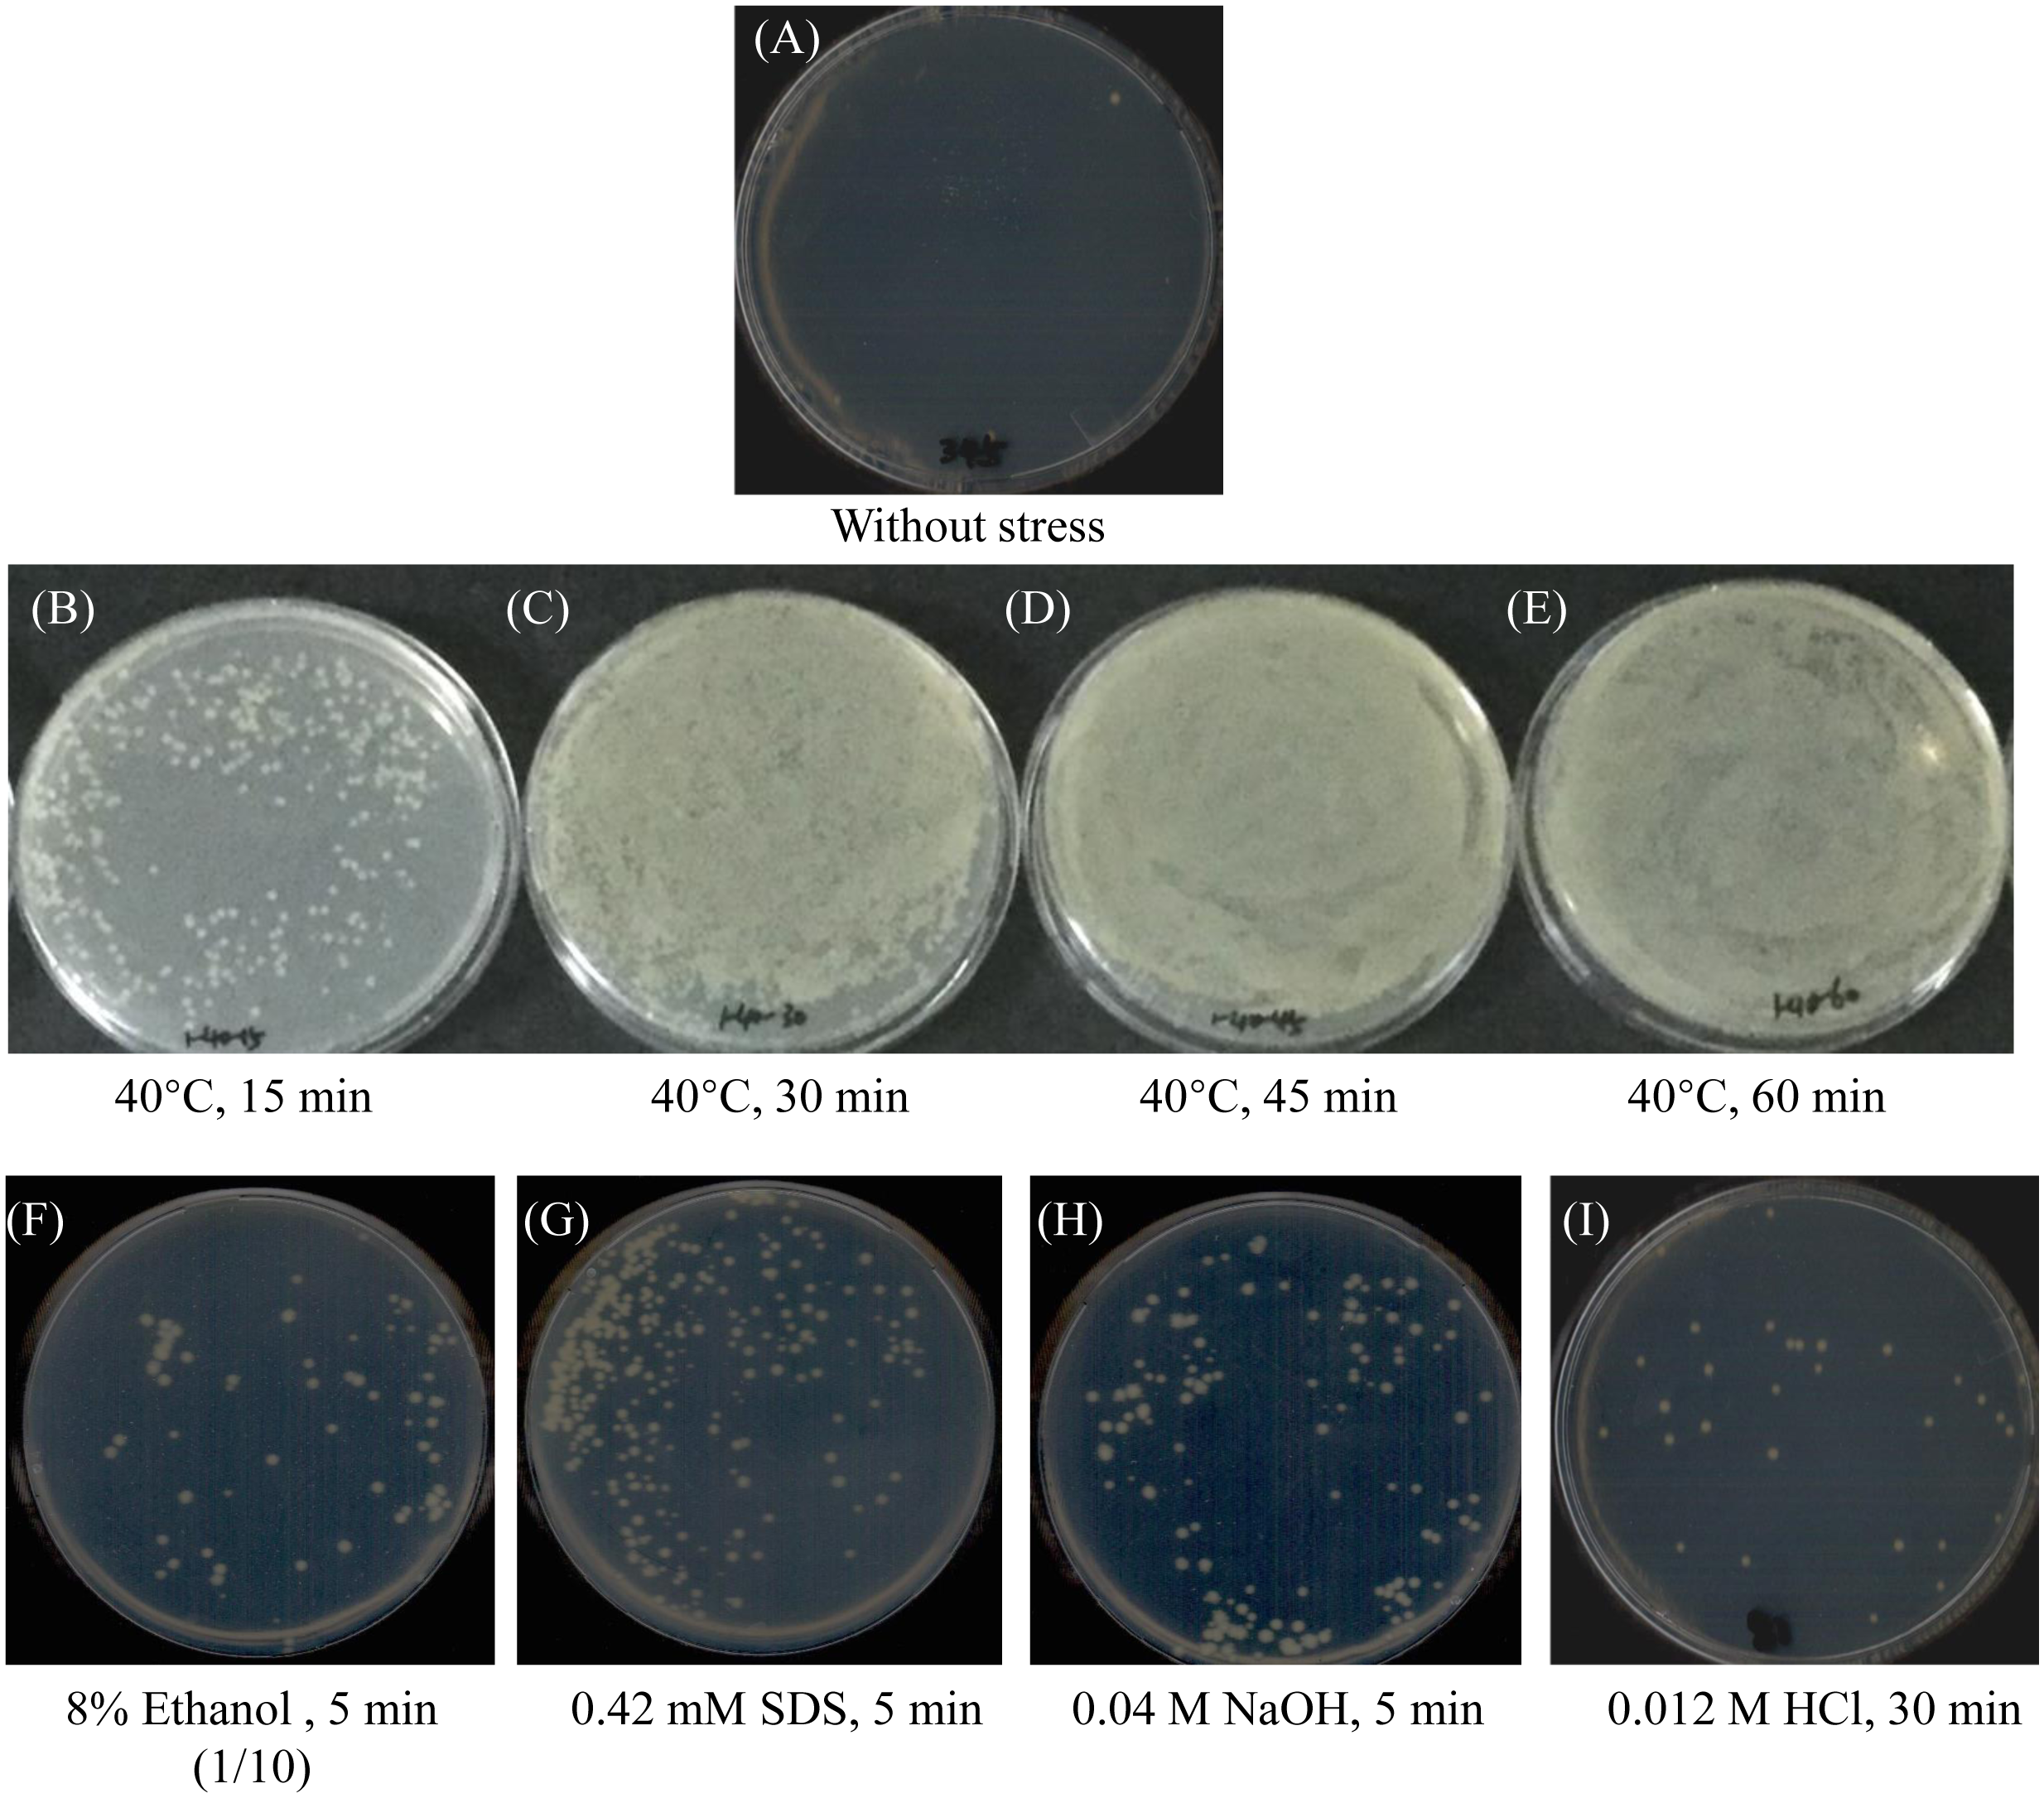

Abstract
Conjugation is the most common horizontal gene transfer (HGT) process that can be affected by environmental change and promote bacterial virulence and drug resistance. However, it is unknown whether environmental changes can influence the conjugation ability of the marine fish pathogen Vibrio harveyi, thereby affecting its pathogenicity and drug resistance. This study systematically analyzes the effect of environmental stress on the ability of V. harveyi to obtain shuttle plasmids from Escherichia coli during conjugation. The results indicate that V. harveyi cannot receive shuttle plasmid pMMB207 without exposure to stress. However, certain stress exposure (37–46°C, 4%–16% ethanol, 0.14–0.56 mM SDS, 0.04~0.05 M NaOH, and 0.012–0.024 M HCl for 5–60 minutes) in the log phase of V. harveyi before conjugation successfully induces the fertility of the V. harveyi recipient in intergeneric mating with E. coli. In particular, ethanol and heat stress showed strong induction with up to 2.5 × 105 and 5.3 × 103 transconjugants when exposed to 16% ethanol for 10 minutes and 40°C for 60 minutes, respectively. Additionally, appropriate levels of NaOH (0.05 M, 10 minutes), SDS (0.42 mM, 5 minutes), and HCl (0.024 M, 5 minutes) lead to 2.3 × 103, 4.5 × 102, and 1.8 × 102 transconjugants, respectively. These results will help establish homologous recombination gene knockout technology and greatly advance molecular theoretical research on V. harveyi. They will also support the establishment of disease prevention and control strategies based on the interruption of the HGT process by environmental regulation.
1 Introduction
About 1.6%–32.6% of genes in each microbial genome are obtained through horizontal gene transfer (HGT), which has become the most important driving force in the evolution of prokaryotes, affecting prokaryotic pathogenicity, drug resistance, metabolism, and so on (Koonin et al., 2001; Thomas and Nielsen, 2005). HGT mainly occurs in prokaryotes through three processes: transformation, transduction, and conjugation. Conjugation transfer is the most likely HGT mode with the highest transfer efficiency in the environment due to the wide range of transferred genes, the lack of a requirement for homology and recombination, and the ability to cross species (Koonin et al., 2001).
Conjugation is a DNA exchange process that forms a “junction bridge” through the contact fusion of the cell membranes of the donor and recipient bacteria. Single-strand plasmids are transported across the cell membrane into recipient cells through the junction bridge, and complementary chains are synthesized to form new plasmid molecules (Thomas and Nielsen, 2005). As a result, conjugation requires the joint participation of the donor bacteria, recipient bacteria, and plasmid. Certain environmental stress can affect bacterial cell membrane status and immune systems, including restriction-modification (R-M) and clustered regu¬larly interspaced short palindromic repeat-associated protein (CRISPR) systems, thus affecting the conjugation efficiency and stability of foreign plasmids in recipient bacteria cells (Schäfer et al., 1994). For example, heat treatment at 50 °C for 20 minutes can inhibit the R-M system of Salmonella typhimurium, thus increasing its fertility in intergeneric mating with Escherichia coli by approximately 200 folds and enhancing the stability of hybrid recombinants (Mojica-a and Middleton, 1971). Additionally, exposure to 4%–20% ethanol for nine minutes increases the fertility of Corynebacterium glutamicum crosses with E. coli by up to 104 folds, probably by affecting the cytoplasmic membrane fluidity (Schäfer et al., 1994).
In recent years, Vibrio harveyi has become the most dominant Vibrio pathogenic bacteria of marine fish in the South China Sea, causing massive economic losses to the aquaculture industry (Deng et al., 2020a; Deng et al., 2020b). It is reported that V. harveyi can obtain foreign DNA through HGT, increasing its pathogenicity and drug resistance, the complexity and variability of Vibrio disease prevention and control, and posing a significant threat to breeding and food safety (Ruwandeepika et al., 2010; Deng et al., 2019; Deng et al., 2020b). In addition, the temperature rise caused by global warming and the environmental pollution caused by human activities can seriously affect the sustainable development of aquaculture (Khoshnevis Yazdi and Shakouri, 2010; Zhou et al., 2021). However, it is unknown whether the environmental changes affect the HGT of V. harveyi, thus impacting their pathogenicity and drug resistance. Furthermore, it was found that the laboratory conjugation transfer efficiency of V. harveyi is extremely low and normally unsuccessful. This precludes the use of conjugation to transfer suicide plasmids from the donor bacteria to the recipient bacteria in order to carry out in-frame gene mutations, seriously limiting research into the regulation of virulence and drug resistance in V. harveyi.
In this study, we investigated the effects of different environmental stresses (heat, ethanol, SDS, acid, alkali, and salinity) on the conjugation efficiency of V. harveyi recipient crosses with E. coli. This will provide new insights into the mechanisms of pathogenicity and drug resistance in V. harveyi, in addition to an important scientific foundation for in-frame deletions and will establish strategies for preventing and controlling outbreaks of V. harveyi disease based on the blocking of the conjugation transfer process.
2 Materials and methods
2.1 Bacterial strains and growth conditions
The bacterial strains and plasmids used in this study are listed in Table 1. The conjugative receptor strain V. harveyi 345 was isolated from a diseased pearl gentian grouper with multi-drug resistance and a median lethal dose of 9.83 × 105 CFU·g−1 (Deng et al., 2019). It was cultured in Luria–Bertani (LB) broth with 2% additional NaCl (LBS) at 28°C. The mobilizable shuttle plasmid pMMB207 (Figure S1) is chloramphenicol (Cm) resistant and can be transferred via conjugation from E. coli to a variety of bacteria including Aeromonas hydrophila, V. alginolyticus, V. campbellii, V anguillarum, and V. parahaemolyticus (Zhang, 2012; Pang, 2015; Liu et al., 2017; Li et al., 2022). The conjugative donor strain, E. coli GEB883-pMMB207, was the GEB883 strain with pMMB207. It was cultured in LB with 20 μg/ml Cm and 0.3 mM diaminopimelate (DAP) at 37°C.
Table 1
| Strains or plasmids | Relevant characteristics | Sources |
|---|---|---|
| Bacterial strains | ||
| V. harveyi 345 | V. harveyi 345: isolated from diseased grouper kidney off the South China Sea coast | (Deng et al., 2019) |
| E. coli GEB883 | Eryr, Tetr,WTE.coli K12 ΔdapA::erm pir RP4-2 ΔrecAgyrA462, zei298::Tn10 | (Nguyen et al., 2018) |
| Plasmids | ||
| pMMB207 | Cmr; Prokaryotic cell expression vector plasmid; Tac-Promoter; stable expression | (Liu et al., 2017) |
The bacterial strains and plasmids used in this study.
2.2 Conjugation assay
V. harveyi 345 was inoculated into an LBS liquid medium and cultured overnight at 28°C with 200 rpm shaking, then diluted 300 times and cultured under the same conditions until the early log phase (OD600nm = 0.5–1.0). The E. coli GEB883-pMMB207 was inoculated into LB liquid medium with 20 μg/ml Cm and 0.3 mM DAP at 37°C with 200 rpm shaking, then the overnight culture was diluted 100 times and cultured under the same conditions until the early log phase (OD600nm = 0.5–1.0).
The early log phase recipient bacterial cells of V. harveyi 345 were exposed to different stress (31–46°C for 15–60 minutes, 4%–16% ethanol for 5–30 minutes, 0.14–0.56 mM SDS for 5–30 minutes, 0.01–0.05 M NaOH for 5–20 minutes, 0.012–0.06 M HCl for 5–30 minutes), and then washed with 3% NaCl for appropriate times (temperature: did not wash, ethanol: washed three times, SDS: washed four times, NaOH: washed two times, and HCl: washed two times) according to the stress conditions. For each stress condition, 500 μL recipient bacterial cells were used to do stress exposure, and then the 500 μL stress-exposed recipient bacterial cells were mixed with 500 μL early log phase donor bacterial cells of E. coli GEB883-pMMB207. In addition, for salinity stress, an overnight culture of V. harveyi 345 was diluted 300 times in LB liquid medium with a final NaCl concentration of 0.5%, 1.0%, 1.5%, and 4.0% and cultured until the early log phase (OD600nm = 0.5–1.0). Then, 500 μL early log phase recipient bacterial cells were mixed with 500 μL early log phase donor bacterial cells. The mixture was centrifugated at 8,000 g for two minutes at room temperature. After removing the supernatant, the precipitation was suspended with 50 μL of 3% NaCl and seeded onto an LBS plate with DAP (0.3 mM). The plate was dried and conjugated for 16 hours at 28°C. The conjunctive plaques were then scraped and re-suspended in 1 mL 3% NaCl and washed once with 3% NaCl. The bacterial suspension was screened on LBS plates with Cm (34 μg/mL) at an appropriate dilution and incubated for 16 hours at 28°C. Firstly, three to four transconjugant candidates of each condition were selected to do PCR verification with the specific primers pMMB207-F (5’-ctactgagcgctgccgcaca-3’) and pMMB207-R (5’-tcgttttatttgatgcctggcag-3’) with a target band of 1877 bp. The PCR action was checked by 1% agarose gel electrophoresis. Then, the number of transconjugants was counted and compared under different stress conditions. The early log phase recipient V. harveyi 345 without exposure to stress (28°C, 3% NaCl, 0% ethanol, 0 mM SDS, 0 M NaOH, or 0 M HCl) was used as the control, and the experiment was conducted three times.
3 Results
Without exposure to stress, the shuttle plasmid pMMB207 cannot be transferred to V. harveyi by conjugation. However, this plasmid’s intergeneric transfer could be optimized by exposing the V. harveyi recipient cells to stress before mating. Compared with untreated controls, fertility was obtained when bacterial cells were exposed to various treatments, including high temperatures, small alcohols (ethanol), detergents (SDS), and pH shifts (Figure 1).
Figure 1
The growth of transconjugants with indicated stress on LBS plates containing 34 μg/mL Cm. (A) Without stress, no transconjugant growth. (B–E) Exposure to 40°C for 15, 30, 45, and 60 minutes, respectively. The conjunctive plaques were suspended in 100 μL of 3% NaCl and screened on LBS plates with 34 μg/mL Cm. (F) Exposure to 8% ethanol for 5 minutes. The conjunctive plaques were suspended in 1 mL of 3% NaCl and 100 μL of the suspension was screened on LBS plates with 34 μg/mL Cm. (G–I) Exposure to 0.42 mM SDS for 5 minutes, 0.04 M NaOH for 5 minutes, and 0.012 M HCl for 30 minutes, respectively. The conjunctive plaques were finally suspended in 100 μL of 3% NaCl and screened on LBS plates with 34 μg/mL Cm.
Generally, ethanol has the largest effect on transconjugation, leading to as many as 2.5 × 105 transconjugants, followed by temperature (5.3 × 103), NaOH (2.3 × 103), SDS (4.5 × 102), and HCl (1.8 × 102) (Figure 2). No transconjugants grew in the absence of heat shock (28°C) or when recipient cells of V. harveyi 345 were heat shocked for 15–60 minutes at 31 and 34°C (Figure 2A). When the recipient cells were heat treated for 30 minutes at 37°C, pMMB207 was successfully transferred into V. harveyi, and 24 transconjugants grew. V. harveyi has a high mating ability when exposed to 40°C for 30–60 minutes, 43°C for 15–60 minutes, and 46°C for 15 minutes (Figure 2A). When exposed to 40°C, the mating ability increased with the extension of processing time (Figure 2A). However, the mating ability decreased as the processing time increased when exposed to 43 and 46°C (Figure 2A). When treated with 4% ethanol for 15 minutes, V. harveyi successfully incorporated the shuttle plasmid pMMB207 (Figure 2B). Relatively high fertility was induced by 4%–8% ethanol for 5–30 min and 12% ethanol for 5–10 minutes, which led to 1,970–4,500 transconjugants (Figure 2B). Additionally, optimal fertility was induced by stress conditions of 12% ethanol for 20–30 minutes and 16% ethanol for 5–10 minutes, which led to 44,770–249,770 transconjugants (Figure 2B). Figure 2C illustrates that exposure to a low concentration of 0.14 mM SDS detergent increased the fertility of V. harveyi as the incubation time increased. However, the opposite trend occurred when exposed to high concentrations of SDS (0.42 and 0.56 mM), and no transconjugants were obtained when exposed for 20–30 minutes. When treated with a medium concentration of 0.28 mM SDS, the transconjugants increased at first (5–20 minutes), then sharply decreased (30 minutes). Acid (HCl) and alkali (NaOH) treatments aided V. harveyi to receive the shuttle plasmid pMMB207 from E. coli via conjugation, especially when V. harveyi was treated with 0.04–0.05 M NaOH for 5–20 minutes, yielding up to 2,300 transconjugants, and when treated with 0.012-0.024 M HCl for 5–30 minutes, generating up to 180 transconjugants (Figures 2D, E). However, V. harveyi nearly failed to mate with E. coli when treated with 0.01–0.03 M NaOH and 0.036–0.06 M HCl (Figures 2D, E). Furthermore, when the overnight culture of V. harveyi 345 was diluted and cultured in LB liquid medium with different NaCl concentrations (0.5%, 1.0%, 1.5%, and 4.0%), no transconjugants were obtained (data not shown). Additionally, 252 transconjugant candidates were selected for PCR verification (Figure S2). Finally, 244 candidates met the target bands with an effective proportion of 96.83%, which confirms the effectiveness of the results.
Figure 2

The induced interspecific mating ability of V. harveyi with exogenous stress. (A) Exposure to 31–46°C for 15–60 minutes; exposure to 28°C was used as the control. (B) Exposure to 4%–16% ethanol for 5–30 minutes. (C) Exposure to 0.14–0.56 mM SDS for 5–30 minutes. (D) Exposure to 0.01–0.05 M NaOH for 5–20 minutes. (E) Exposure to 0.012–0.06 M HCl for 5–30 minutes. Values are mean ± standard error of the mean (n = 3).
4 Discussion
Here, we systematically studied the efficiency of foreign plasmid conjugation transfer into V. harveyi after exposure to different stresses and found that certain stress exposures, such as temperature, acid, alkali, SDS, and ethanol, can significantly improve the fertility of V. harveyi recipients in intergeneric mating with E. coli. This partly verifies our conjecture that warmer temperatures and antibiotic pollution could probably enhance bacterial antibiotic resistance and bacterial infection by promoting the HGT of virulence genes and antibiotic resistance genes, thus increasing the complexity and diversity of disease control (Deng et al., 2020a; Deng et al., 2020b; Deng et al., 2020c). Therefore, the results of this study have important theoretical significance for establishing disease prevention and control strategies by interrupting the HGT process with environmental regulation.
The state of the recipient cell membrane is a crucial factor affecting the formation of the junction bridge, thereby affecting conjugation transfer (Thomas and Nielsen, 2005). Genco and Clark (1988) reported that the outer membrane protein OmpA of the receptor bacteria can stabilize the junction bridge with the donor bacteria and promote the fertility of E. coli, S. typhimurium, and Neisseria cinerea. Sherburne and Taylor (1997) found that the deletion of lipid A synthesis genes rfaD and rfaE in S. typhimurium contributes to the truncation of lipid A, the reduction of porin by more than 90%, the change of cell membrane permeability, and the reduction of conjugation efficiency by 10–100 folds. Furthermore, successfully escaping the splicing effect of sequence-specific restriction endonucleases in the host cell immune system (R-M system, CRISPR, etc.) is another barricade to the success of conjugation transfer (Hickey and Hirshfield, 1990).
Heat stress can change the permeability of bacterial cell membranes (Panja et al., 2008). During DNA transformation, a heat pulse (0→42°C) can release lipids, denature membrane proteins, considerably lower cellular outer membrane fluidity, and consequently form pores on cell surfaces, allowing the DNA to cross the outer membrane barrier (Panja et al., 2008). Furthermore, Mojica-a and Middleton (1971) found that exposure to 50 °C for 20 minutes can increase the fertility of S. typhimurium by nearly 200 folds by inactivating its R-M system. Ethanol treatment, like heat, leads to changes in protein composition and an increased ratio of saturated to unsaturated fatty acids in the cytoplasmic membrane (Piper, 1995). Protein denaturation and fatty acid profile changes in the cell can occur as a consequence of exposure to pH shifts or detergents (Hickey and Hirshfield, 1990; Adamowicz et al., 1991; Bhuyan, 2010). Therefore, exposure to temperature, ethanol, SDS, acid, and alkali induces the fertility of V. harveyi recipients, probably by increasing its membrane permeability and/or inactivating the immune system. Furthermore, a lower temperature or concentration of stress cannot effectively change the cell membrane and immune system, whereas a higher temperature or concentration of stress is probably lethal to the cells and thus cannot induce the fertility of the recipients (Schäfer et al., 1994).
It should be pointed out that in the process of homologous recombination gene knockout mediated by suicide plasmid of pathogenic bacteria such as Vibrio (Val et al., 2012), conjugation transfers the recombinant suicide plasmid from the donor bacteria to the recipient bacteria and plays a key role in the success of gene knockout. However, due to the extremely low efficiency of V. harveyi fertility, or even V. harveyi that cannot be conjugated, there is no effective mutation system to study its pathogenesis and drug resistance. Based on our research, a breakthrough to improve the conjugation efficiency of V. harveyi has occurred, and we have already established homologous recombination gene knockout technology based on heat shock, ethanol, SDS, acid, and alkali stimulation, which has greatly promoted the research into the molecular mechanism of V. harveyi (Deng et al., 2017a; Deng et al., 2017b; Zhang et al., 2021).
To summarize, environmental changes affect the acquisition of foreign plasmids by V. harveyi recipients, thus affecting the evolution of bacterial virulence and drug resistance. Changes in the fertility of V. harveyi occur by affecting the status of the cell membrane and the activities of the immune system, but the specific mechanism needs to be further studied. In the future, we propose to conduct research in the following three areas: (1) how environmental stress regulates the conjugation of V. harveyi to obtain foreign plasmids at the cellular and molecular levels; (2) the regulation of environmental changes on the fertility of more V. harveyi strains and other typical aquaculture pathogens, including Vibrio, Aeromonas, and Edwardsiella; and (3) the regulation of environmental changes on the efficiency of other ori-plasmid conjugation transfer into typical aquaculture pathogens. In doing so, we will develop disease prevention and control strategies based on environmental regulation to block the HGT process.
Statements
Data availability statement
The raw data supporting the conclusions of this article will be made available by the authors, without undue reservation.
Author contributions
YD contributed to conception and design of the study, wrote the first draft of the manuscript. SG and HM conducted the experiment. LX performed the statistical analysis. CC wrote sections of the manuscript. JF supervised the study. All authors contributed to manuscript revision, read, and approved the submitted version.
Funding
This work was supported by the Central Public-Interest Scientific Institution Basal Research Fund, CAFS (2022GH03), the Guangzhou Science and Technology Program (202201010162), the National Natural Science Foundation of China (NSFC) (31902415), the Central Public-Interest Scientific Institution Basal Research Fund, the South China Sea Fisheries Research Institute, CAFS (2021SD15), the Natural Science Fund of Guangdong (2019A1515011833), and the China Agriculture Research System (CARS-48).
Acknowledgments
We would like to thank International Science Editing (http://www.internationalscienceediting.com) for editing this manuscript.
Conflict of interest
The authors declare that the research was conducted in the absence of any commercial or financial relationships that could be construed as a potential conflict of interest.
Publisher’s note
All claims expressed in this article are solely those of the authors and do not necessarily represent those of their affiliated organizations, or those of the publisher, the editors and the reviewers. Any product that may be evaluated in this article, or claim that may be made by its manufacturer, is not guaranteed or endorsed by the publisher.
Supplementary material
The Supplementary Material for this article can be found online at: https://www.frontiersin.org/articles/10.3389/fmars.2023.1083714/full#supplementary-material
References
1
Adamowicz M. Kelley P. M. Nickerson K. W. (1991). Detergent (sodium dodecyl sulfate) shock proteins in Escherichia coli. J. bacteriology173 (1), 229–233. doi: 10.1128/jb.173.1.229-233.1991
2
Bhuyan A. K. (2010). On the mechanism of SDS-induced protein denaturation. Biopolymers: Original Res. Biomolecules93 (2), 186–199. doi: 10.1002/bip.21318
3
Deng Y. Q. Feng J. Bei L. Su Y. L. (2017b). A thermal shock-based vibrio harveyi homologous recombinant gene knockout method, Chinese patent: CN107904228B2022.09.06. Available at: http://www2.soopat.com/Patent/201711295414?lx=FMSQ.
4
Deng Y. Q. Wu J. J. Feng J. Su Y. L. (2017a). Method for improve genetic transformation of Vibrio harveyi, Chinese patent: CN108165571B2022.06.24. Available at: http://www2.soopat.com/Patent/201711293764.
5
Deng Y. Q. Xu L. W. Chen H. X. Liu S. L. Guo Z. X. Cheng C. H. et al . (2020a). Prevalence, virulence genes, and antimicrobial resistance of vibrio species isolated from diseased marine fish in south China. Sci. Rep.10 (1), 1–8. doi: 10.1038/s41598-020-71288-0
6
Deng Y. Q. Xu L. W. Liu S. L. Wang Q. Guo Z. X. Chen C. et al . (2020b). What drives changes in the virulence and antibiotic resistance of Vibrio harveyi in the south China Sea? J. fish Dis.43 (8), 853–862. doi: 10.1111/jfd.13197
7
Deng Y. Q. Xu H. D. Su Y. L. Liu S. L. Xu L. W. Guo Z. X. et al . (2019). Horizontal gene transfer contributes to virulence and antibiotic resistance of Vibrio harveyi 345 based on complete genome sequence analysis. BMC Genomics20 (1), 1–19. doi: 10.1186/s12864-019-6137-8
8
Deng Y. Q. Xu L. W. Zhang Y. Q. Guo Z. X. Feng J. (2020c). Analysis of virulence genes and antibiotic resistance of Photobacterium damselae isolated from marine fishes in coastal south China. Acta Microbiologica Sin.2020, 60(11). doi: 10.13343/j.cnki.wsxb.20200129
9
Genco C. A. Clark V. L. (1988). Role of outer-membrane proteins and lipopolysaccharide in conjugation between Neisseria gonorrhoeae and Neisseria cinerea. Microbiology134 (12), 3285–3294. doi: 10.1099/00221287-134-12-3285
10
Hickey E. W. Hirshfield I. N. (1990). Low-pH-induced effects on patterns of protein synthesis and on internal pH in Escherichia coli and Salmonella typhimurium. Appl. Environ. Microbiol.56 (4), 1038–1045. doi: 10.1128/aem.56.4.1038-1045.1990
11
Khoshnevis Yazdi S. Shakouri B. (2010). The effects of climate change on aquaculture. Int. J. Environ. Sci. Dev.1 (5), 378. doi: 10.7763/IJESD.2010.V1.73
12
Koonin E. V. Makarova K. S. Aravind L. (2001). Horizontal gene transfer in prokaryotes: quantification and classification. Annu. Rev. Microbiol.55 (1), 709–742. doi: 10.1146/annurev.micro.55.1.709
13
Li W. J. Xue T. Y. Lian L. L. Ren J. L. Tang F. Xue F. et al . (2022). vcrV gene affects translocation of T3SS1 effector protein and biological characteristics of Vibrio parahaemolyticus. Microbiol. China49 (5), 1608–1618. doi: 10.13344/j.microbiol.china.211147
14
Liu J. X. Zhao Z. Deng Y. Q. Shi Y. Liu Y. P. Wu C. et al . (2017). Complete genome sequence of Vibrio campbellii LMB 29 isolated from red drum with four native megaplasmids. Front. Microbiol.8, 2035. doi: 10.3389/fmicb.2017.02035
15
Mojica-a T. Middleton R. B. (1971). Fertility of Salmonella typhimurium crosses with Escherichia coli. J. Bacteriology108 (3), 1161–1167. doi: 10.1128/jb.108.3.1161-1167.1971
16
Nguyen A. N. Disconzi E. Charrière G. M. Destoumieux-Garzón D. Bouloc P. Le Roux F. et al . (2018). csrB gene duplication drives the evolution of redundant regulatory pathways controlling expression of the major toxic secreted metalloproteases in Vibrio tasmaniensis lgp32. MSphere3 (6), e00582–e00518. doi: 10.1128/mSphere.00582-18
17
Pang M. D. (2015). Study on genomic characteristics and virulence related genes of aeromonas hydrophila epidemic strains (Nanjing: Agricultural University).
18
Panja S. Aich P. Jana B. Basu T. (2008). How does plasmid DNA penetrate cell membranes in artificial transformation process of Escherichia coli? Mol. membrane Biol.25 (5), 411–422. doi: 10.1080/09687680802187765
19
Piper P. W. (1995). The heat shock and ethanol stress responses of yeast exhibit extensive similarity and functional overlap. FEMS Microbiol. Lett.134 (2-3), 121–127. doi: 10.1111/j.1574-6968.1995.tb07925.x
20
Ruwandeepika H. A. D. Defoirdt T. Bhowmick P. P. Shekar M. Bossier P. Karunasagar I. (2010). Presence of typical and atypical virulence genes in vibrio isolates belonging to the Harveyi clade. J. Appl. Microbiol.109 (3), 888–899. doi: 10.1111/j.1365-2672.2010.04715.x
21
Schäfer A. Kalinowski J. Pühler A. (1994). Increased fertility of Corynebacterium glutamicum recipients in intergeneric matings with Escherichia coli after stress exposure. Appl. Environ. Microbiol.60 (2), 756–759. doi: 10.1128/aem.60.2.756-759.1994
22
Sherburne C. Taylor D. E. (1997). Effect of lipopolysaccharide mutations on recipient ability of Salmonella typhimurium for incompatibility group h plasmids. J. Bacteriology179 (3), 952–955. doi: 10.1128/jb.179.3.952-955.1997
23
Thomas C. M. Nielsen K. M. (2005). Mechanisms of, and barriers to, horizontal gene transfer between bacteria. Nat. Rev. Microbiol.3 (9), 711–721. doi: 10.1038/nrmicro1234
24
Val M. E. Skovgaard O. Ducos-Galand M. Bland M. J. Mazel D. (2012). Genome engineering in Vibrio cholerae: a feasible approach to address biological issues. PloS Genet.8 (1), e1002472. doi: 10.1371/journal.pgen.1002472
25
Zhang Y. F. (2012). Identification and functional study of spermidine binding protein gene of vibrio anguillarum (Qingdao University of Science and Technology). Available at: https://kns.cnki.net/KCMS/detail/detail.aspx?dbcode=CMFD&filename=1013160574.nh.
26
Zhang Y. Q. Deng Y. Q. Feng J. Guo Z. X. Mao C. Chen H. X. et al . (2021). CqsA inhibits the virulence of Vibrio harveyi to the pearl gentian grouper (♀ Epinephelus fuscoguttatus×♂ epinephelus lanceolatus). Aquaculture535, 736346. doi: 10.1016/j.aquaculture.2021.736346
27
Zhou A. G. Zhang Y. Xie S. L. Chen Y. L. Li X. Wang J. et al . (2021). Microplastics and their potential effects on the aquaculture systems: a critical review. Rev. Aquaculture13 (1), 719–733. doi: 10.1111/raq.12496
Summary
Keywords
Vibrio harveyi , stress exposure, horizontal gene transfer, induced fertility, environmental regulation
Citation
Deng Y, Gao S, Xu L, Cheng C, Ma H and Feng J (2023) First insight into how stress exposure triggers Vibrio harveyi recipient successful conjugation. Front. Mar. Sci. 10:1083714. doi: 10.3389/fmars.2023.1083714
Received
29 October 2022
Accepted
30 January 2023
Published
13 February 2023
Volume
10 - 2023
Edited by
Francisco Vargas-Albores, National Council of Science and Technology (CONACYT), Mexico
Reviewed by
Javier Santander, Memorial University of Newfoundland, Canada; Biswajit Maiti, Nitte University, India
Updates
Copyright
© 2023 Deng, Gao, Xu, Cheng, Ma and Feng.
This is an open-access article distributed under the terms of the Creative Commons Attribution License (CC BY). The use, distribution or reproduction in other forums is permitted, provided the original author(s) and the copyright owner(s) are credited and that the original publication in this journal is cited, in accordance with accepted academic practice. No use, distribution or reproduction is permitted which does not comply with these terms.
*Correspondence: Yiqin Deng, yiqindd@126.com; Juan Feng, juanfeng@scsfri.ac.cn
This article was submitted to Marine Fisheries, Aquaculture and Living Resources, a section of the journal Frontiers in Marine Science
Disclaimer
All claims expressed in this article are solely those of the authors and do not necessarily represent those of their affiliated organizations, or those of the publisher, the editors and the reviewers. Any product that may be evaluated in this article or claim that may be made by its manufacturer is not guaranteed or endorsed by the publisher.